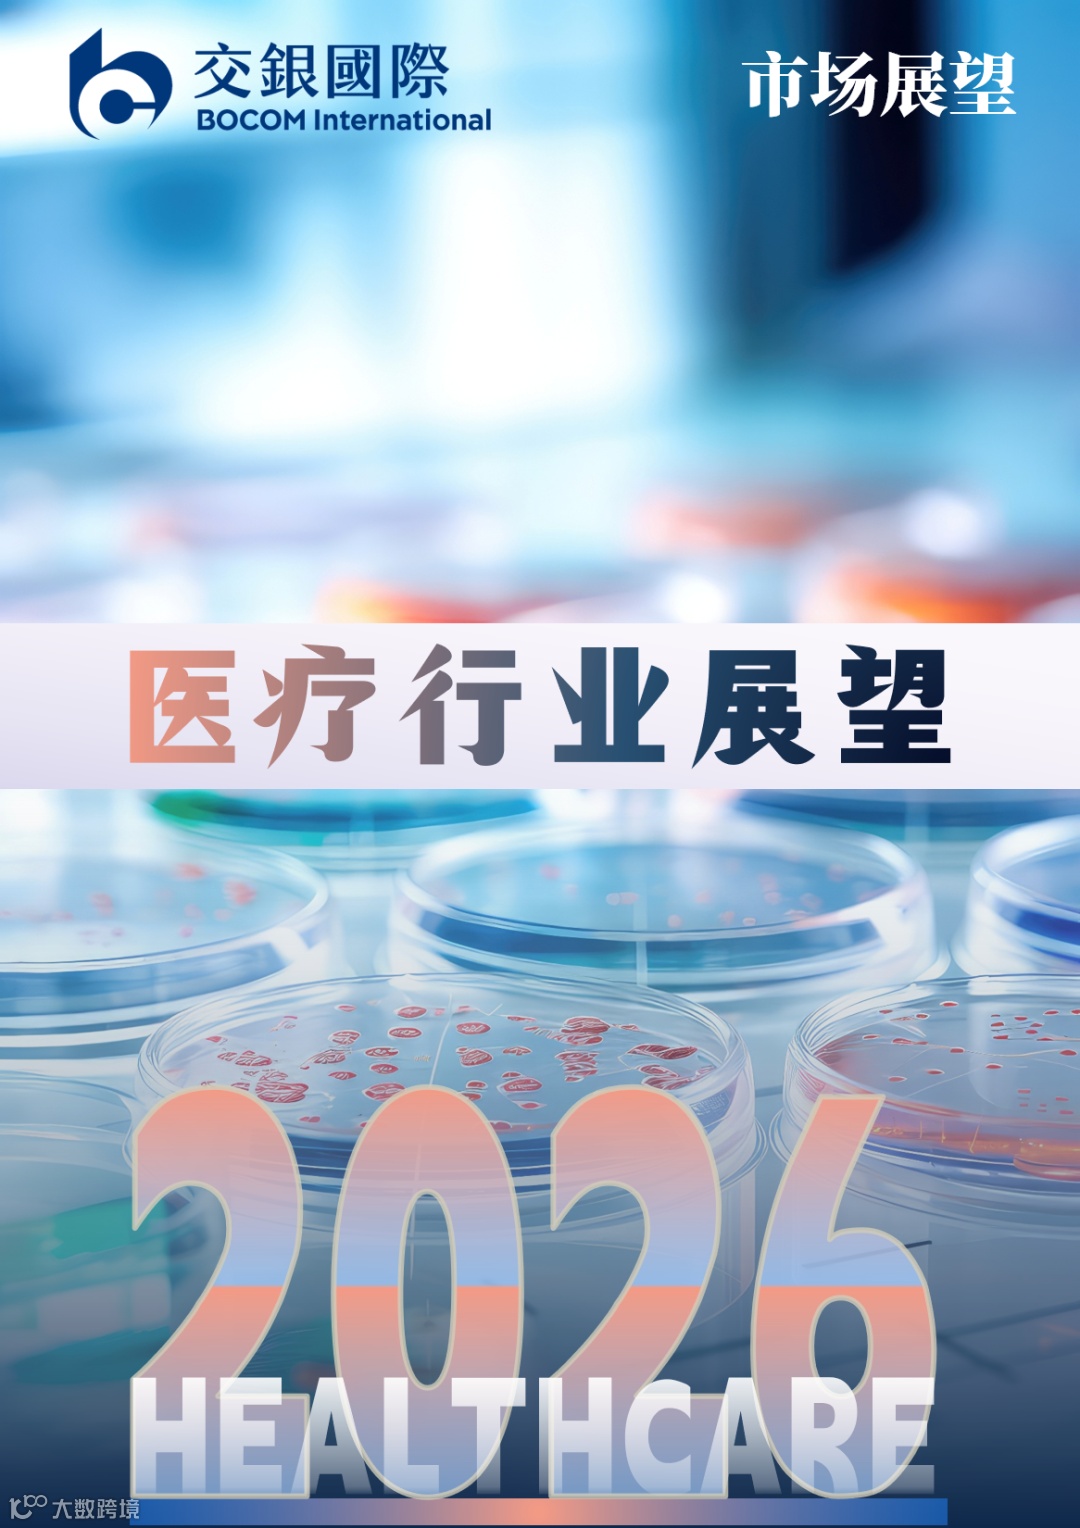

/ 导语
2026年,全球经济确定性增强,中国站在"十五五"开局的新起点。从"谋定而动"到"乘势而进",政策发力、产业升级与科技突破形成合力,结构性机遇正在涌现,新的市场主题正在构筑。
蓝图既定,交银国际宏观策略联合行业团队,系统梳理资产配置与行业投资的核心逻辑,奋楫赴新程。

▲扫码阅读全文


全球宏观


分析师:李少金、谭伟民
2025年全球经济韧性普遍超出年初预期,AI科技周期未完待续,政策保持连贯性。2025年的“谋定而动”,为2026年“乘势而进”奠定了基础,无论是货币政策的宽松延续、财政政策的积极发力,还是产业政策的战略聚焦,都将在2026年中继续发挥作用,成为我们投资布局的重要锚点。展望2026年,随着外部环境向有序回归,确定性增强之下,风险偏好上行,资产配置核心逻辑向攻守平衡转换。
乘科技之势:AI投资方兴未艾
人工智能技术发展已超越单纯技术突破。从历史经验来看,每一次重大技术革命都会经历“技术突破→基础设施建设→应用爆发→经济变革”的完整周期,而当前AI产业仍处基础设施建设的早期阶段。2025年科技巨头在数据中心和算力上的巨额投资,本质上是在为未来十年的应用爆发打基础。同时,AI应用的渗透率虽在快速提升,但企业级市场开发才刚刚开始,消费级应用“杀手级”产品尚未真正出现,意味着当前投资规模相较未来仍有较大市场空间。进入2026年,预计随着模型训练效率提升、推理成本下降、边缘计算普及,AI应用的经济性将进一步改善,商业化进程将会持续加速。产业生态也将从“百花齐放”向“优胜劣汰”阶段,真正具有商业价值的应用会脱颖而出,开始贡献可观的收入和利润,实现从投资驱动到盈利驱动的转变。
乘政策之势:全球货币财政政策的共振
2026年全球宏观政策环境的最大特征是“共振”——主要经济体货币同步宽松、财政主动发力:1)美联储降息周期将在2026年延续,尽管降息空间及节奏会受通胀和需求制约;欧央行、英国央行仍同处降息轨道;日本央行虽已退出负利率并向政策正常化过度,但新政府上台后,步伐或更偏谨慎;中国央行则有望维持适度宽松立场,继续为经济修复提供充裕流动性支持。2)全球主要经济体财政政策在2026年将维持扩张。美国“大而美”法案支出将在2026年开始发力,对需求侧的拉动效应将随之显现;中国迎“十五五”开局之年,财政政策将明显发力,相关产业支持力度显著提升;欧元区、日本财政扩张均呈蓄势待发状态。全球主要央行货币、财政政策的方向一致性,有望继续为风险资产提供政策窗口期。
大类资产展望:确定性之下的风险偏好上行
展望2026年,全球经济宏观环境向有序回归,经济增长一定程度上具韧性,利率或维持限制性水平。在增长韧性、通胀、利率均偏高的环境下,资产配置的核心逻辑向攻守平衡转换。港股:盈利可期, “慢牛” 延续。估值处于合理区间,性价比突出;流动性环境持续改善,南向资金和海外资金回流;中国经济的结构性亮点(AI科技、反内卷、内需修复)预计将开始在盈利层面兑现。美股:“泡沫” 短期难证伪,风格待转换。科技巨头受益于AI革命和资本支出扩张的科技龙头企业,凭借强劲的盈利增长和技术壁垒,仍具备估值支撑,但需警惕投资放缓和信贷风险;此外,美股大小盘分化有望收窄,小盘股和周期股或将迎来补涨机会。美债:利率中枢 “易升难降” 格局难改,关注重点仍是长端利率因通胀、财政、政策不确定性而承压,收益率曲线或趋陡峭化。


房地产


分析师:谢骐聪
中国内地房地产:“十五五”开局之年,寻找新均衡
展望2026年,我们预计行业在政策大力托举下探索新的发展模式,整体虽仍或面临一定挑战,但“好房子”和“好城市”带来的结构性机会已显现。我们预计2026年全国商品房销售面积将为9.0 - 9.5亿平方米区间(对比2024年的约9.7亿平方米)同时,由于销售面积和全国平均房价的结构性调整(部分被高端项目入市对冲),我们预计全国商品房销售金额预计将在约10 - 11万亿元人民币,其中包括约8 - 9万亿元人民币商品住宅销售。我们对中国内地房地产的偏好排序为:估值不高的国企/国企背景开发商>拥有一/二线城市土地储备的民企龙头>其他民企开发商。
中国香港房地产:拥抱拐点与复苏的到来
经历多年调整后,我们认为以下变化是市场复苏的关键支撑:1)宏观不确定性的改善(尤其是降息);2)政策环境的重大宽松;3)基础需求驱动因素的回归。我们认为复苏是循序渐进的过程,预计投资者将优先布局住宅板块的复苏;其次是优质零售资产;最后是核心写字楼。我们预计住宅租金水平2026与2027年按年均增长约3%,而正向净租金回报率与降息将提升用户购买力并刺激投资需求,因此我们预计住宅价格在2026/2027年分别上涨5%/5%。
另外,在本地消费情绪企稳与入境旅客增加的支持下,我们认为零售板块正处于复苏轨道,预计未来12个月核心地段零售租金温和增长,社区商场租金增长约3–5%,而写字楼空置率已见顶,核心CBD连续八个季度录得正净吸纳量,我们预计租金企稳并为2026年反弹奠定基础。
综合各项信号与证据显示,中国香港实体市场正在触底或即将迎来反转。我们预计其内在价值将逐步释放,投资者若能在周期早期阶段进行布局,将有望捕捉到即将到来的重估行情。


科技


分析师:王大卫,童钰枫
人工智能景气度或继续保持高位
我们认为本轮生成式人工智能所带来的技术进步浪潮范围大,影响深远且牵涉产业链环节众多。我们认为AI基础设施建设至少在2026年或继续强劲增长。我们统计海外主要云厂商资本开支,在2024/25年同比分别增长60%以上的基础上,2026年或继续增长30%以上。我们发现主要云厂商云业务收入在2Q25之后加速,达到近年来高点。剔除甲骨文之后,主要云厂商在手订单RPO数量在2025年加速上升,接近资本开支增速。虽然云厂商资本开支相对于经营性现金流的占比处于相对高位,我们认为总体过度投资的风险可控。我们认为计算加速/网络通信芯片供应或上升,但总体需求处于高位,依然存在供不应求态势。我们认为HBM存储芯片供应紧张或在2026年有所缓解,但总体存储器价格或在2026全年保持坚挺。
“十五五”开局之年,国产替代产业链面临机会
我们继续看好国产替代在关键产业链的投资机会,并认为“十五五”期间的政策支持或使国产替代进程加速。我们看到中国内地云服务商资本开支2025年或同比增49%,并认为资本开支或在2026/27年保持高位。我们看到国产算力芯片呈现百花齐放态势,技术上取得长足进步。我们同时认为国产算力产业链,包括晶圆代工、存储器、半导体设备;或都在“十五五”国产化加速创新的大背景下受益。
终端需求复苏继续分化
我们看到终端需求复苏温和,与人工智能强相关的服务器需求依然旺盛。考虑本轮存储器上行周期价格上涨幅度和时长都超我们预期,包括晶圆代工在内的其他产业链进一步挤压利润空间,我们对2026年全球消费电子需求相对谨慎,预测手机/PC同比增长-0.3%/0%。
风险提示:AI终端变现不及预期;核心标的估值处于高位;地缘不确定性。

医药


分析师:丁政宁、诸葛乐懿
稳中向好趋势不改,内部分化或加剧,选股偏好回归基本面
如我们此前预期,医药行业2025年迎来关键转折。2026年,我们认为板块稳中向好态势延续,但影响市场表现的核心因素(政策、基本面、海外投融资环境、资金面等)或呈分化态势。展望板块表现和选股逻辑,我们判断,2026年:1)板块本身低估+催化剂有望继续驱动向上行情,而创新研发的价值兑现有望进一步推动整体估值中枢上移;2)部分细分板块/标的领涨后,后续选股或将重回基本面和估值,即存在基本面预期差、当前仍被低估的个股。
创新药/处方药:短期关注出海交易和业绩表现,创新迭代驱动长期价值兑现
2026年继续看好在医药行业中布局创新药,关键短期催化剂包括BD/海外临床数据等出海进展、医保/商保纳入、盈亏平衡点达到等。对创新转型步伐较快的处方药企,集采影响递减,新大单品上市放量叠加授权合作收入逐步常态化,港股龙头收入和净利润增速有望稳定在双位数。
CXO:底部反转后关注行业整合趋势
较快业绩增速有望保持,但在美国药品相关监管收紧、新药研发难度升级的长期大趋势下,行业整合或才刚拉开序幕,高景气度赛道中的头部玩家有较高的长期确定性。
民营医院:优选高质量民营医院标的
随着控费压力释放、落后产能出清,民营医疗机构有望重回较快增长通道。推荐短期业绩反弹可期、长期扩张路径清晰的优质标的。
消费




分析师:肖凯希、钱昊
2025年消费小幅回暖,2026年有望延续温和增长
2025年以来,中国内地消费市场延续温和复苏态势,1-10月社会消费品零售总额累计同比增长4.3%,显示整体需求处于恢复通道。然而,消费者信心指数虽逐季回升但仍徘徊在荣枯线下,储蓄意愿维持高位、CPI低位运行,均反映出消费者偏谨慎的心态。因此我们看到,性价比趋势下多数细分行业仍面临需求偏软与竞争加剧的双重压力;但另一方面,消费者更加重视情绪价值,同时“以旧换新”等政策有效带动家电等品类,相关子行业成为年内消费主线。
展望2026年,消费有望延续温和增长的新常态,其核心特征是总体需求增速偏缓,但消费理性化与需求层级的上移不断推动结构性分化,进而成为细分市场的重要增长动力。市场将逐步构建新平衡,以挖掘消费者需求为核心,更加重视经营效率提升;企业需精准洞察消费趋势,通过产品、渠道、技术创新与供应链优化,把握新常态下的结构性机会。
消费市场变局下的机遇与挑战,增长动能重塑
当前消费市场呈现多维变革趋势,其核心是向以消费者为中心演进。
在消费趋势层面,性价比与情绪价值共同主导当前的消费决策,这为企业在产品创新和品牌建设方面提供了重点方向。
在渠道层面,新业态不断涌现,线上线下融合加深,渠道布局日益多元;企业若能顺应渠道变化、优化消费者触达方式,将在市场份额提升和运营效率优化方面获得关键机会。
在技术层面,人工智能正逐步渗透行业各个环节,未来2-3年有望深度融入核心业务环节,覆盖营销、供应链、产品开发等关键领域,这一趋势可能催生新的商业模式并重塑竞争格局;我们相信人工智能的运用将有助企业提升管理运营效率,同时长远来看,可以帮助企业完善“货找人”新生态下的企业竞争力。
综合来看,在需求温和增长与多维变革的背景下,消费企业可在产品定位、渠道布局、技术应用方面抓取更大的增长机会,精确识别需求并提升运营效率。此外,在中国内地消费市场渐趋成熟的背景下,开拓海外市场已成为企业构建第二增长曲线的重要战略路径。
2026年行业主线
我们建议采取攻守兼备的策略。一方面,可配置拥有稳定现金流、需求韧性强的防御性板块作为基石;另一方面,积极布局具有高成长潜力的结构性机会,并密切关注新消费趋势与技术变革带来的产业重塑潜力。当前,企业的利润驱动因素正从单一的规模效应,转向品牌溢价、渠道创新、供应链效率与技术优势等复合能力的竞争。
重点可聚焦于三类企业:一类是受益于供需改善、有望通过效率提升释放盈利弹性的公司;第二类是敏锐捕捉消费趋势、具备快速增长潜力的细分龙头;第三类是具备稳健增长基础、护城河坚固并拥有抗周期能力的行业龙头。
风险提示:1)宏观不确定性;2)大宗商品通胀高于预期;3)国际贸易不确定性;4)消费相关刺激政策力度不及预期。
汽车




分析师:陈庆、李柳晓
乘用车:政策刺激后高位整固 , L3进入商用元年
2026年乘用车行业将步入高位整固期,我们预计全年乘用车零售销量同比微增 0.3% 至 2445 万辆,新能源渗透率突破60%,主要增长动力来自自主品牌在插混与纯电技术的产品迭代与规模化成本优势。出口方面,中国汽车出海将转向本土化制造,应对贸易不确定性,我们预计2026年海外总销量将达750-800万辆。同时,重点关注L3商用迈入快车道。
重卡:政策红利释放与新能源渗透加速
预计2026年中国内地重卡销量(含出口)约110万辆,同比增5%,下半年好于上半年。若报废更新政策延续或升级,销量或超基准情景:燃油车存量更新中优势释放+估值吸引;数据中心及大缸径发动机国产替代加速+AI数据中心需求爆发+MTU外资订单饱满。
人形机器人:“技术突破”走向“商业兑现”
随着机器人售价下探,我们预计2026年C端商业化更加顺畅。从投资角度,机器人板块股价进入整固期,关注情绪面、技术突破、以及量产落地。经过年底阶段的波动后,2026 年板块有望进入整固与理性回归阶段,投资者将更关注企业实际落地能力与业绩兑现情况。重点关注:特斯拉 Optimus量产订单与 Gen3 样机发布等节点、零部件企业实际订单,以及国产整机厂供应链订单的落实。
锂电:储能需求强劲,产业链盈利改善预期增强
2026 年,我们预计全球锂电池总需求同比增长约22%,储能增速强于动力。锂电中上游盈利能力大概率将延续修复趋势,但对于碳酸锂价格上行仍需保持谨慎态度,关键变量在于江西锂云母矿区的合规性审查进展以及宁德时代枧下窝矿山能否于2026年顺利恢复生产。固态电池方面,2027 年被认为是量产节点,关注硫化物固态电解质的产能落地。同时警惕关税扰动对出口的影响。
新能源与
公用事业




分析师:郑民康、文昊
“十五五”规划前瞻:风/光增量明确,促进消纳重要性提升
在“十五五”规划即将迎来开局之年,正值我国的新能源发电行业身处发展的关键时期,“1360号文”提出发展目标到2030年满足全国每年新增200GW以上新能源的消纳需求。2025年,在上半年政策推动一轮抢装后,我们预期全年内地风/光的装机旺季将较往年温和,但维持全年装机总量创历史新高的预测(风/光分别达98/295GW)。展望2026年,我们预期中国内地光伏装机或将继续保持280GW的高位;风电装电方面,在过去招标量饱满的支撑下,仍有望同比增长约11%至110GW。
光伏行业去产能趋势延续,龙头优势仍显著
在“反内卷”政策导向的推动下,光伏材料的主要企业通过自律减产和限销挺价等措施,有效改善了供需情况。我们看到行业“反内卷”已逐步推动行业盈利改善,龙头企业有望受益于推出的提高技术指标等去产能政策,同时仍有能力保持盈利或稳健经营,市场化出清下,预计盈利或会逐渐改善,竞争优势仍显著。
行业偏好顺序为:多晶硅>逆变器/储能>运营商>光伏玻璃>电池片
协鑫科技在颗粒硅盈利优势明显,低电耗符合政策导向,行业“反内卷”推动多晶硅价格大涨,产能收储若能落地将推动价格进一步上涨。另外,阳光电源受惠大储需求超预期爆发式增长,公司作为全球储能系统龙头,充分受益于该趋势,海外出货占比持续提升,毛利率保持高位,同时大力布局需求爆发式增长的AIDC电源业务,有望成为新的重要增长点。
交银国际研究团队
本文节选自2025/12/10已发布之交银国际已发布研究报告《交银国际 | 2026市场展望:奋楫赴新程》。
更多往期精选文章>>>











